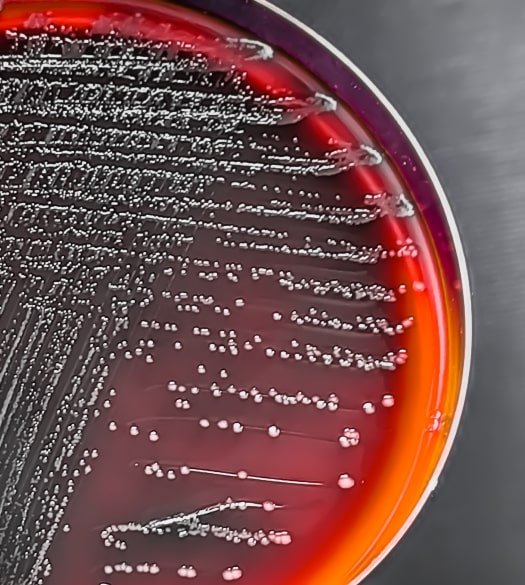

Siempre estamos abiertos a fabricar productos químicos según las necesidades de nuestros clientes. Si estás buscando algo específico, no dudes en contactarnos; estaremos encantados de ayudarte.
Hello world!
Welcome to WordPress. This is your first post. Edit or delete it, then start writing!